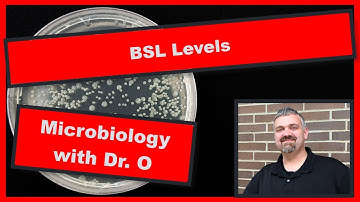
BSL Biosafety Levels:  Microbiology Lab

⬇ DOWNLOAD NOW
Kalau muncul iklan pop-up, tutup lalu klik tombol kembali
Download lagu Understanding Biosafety Levels secara gratis hanya untuk keperluan promosi. Dukung artis favorit kamu dengan membeli musik original di iTunes atau platform resmi lainnya.
 Biosafety Levels Explained: Everything You Need To Know
Biosafety Levels Explained: Everything You Need To Know
 Biosafety Level 3 Lab Entry
Biosafety Level 3 Lab Entry
BSL Biosafety Levels: Microbiology Lab
BSL Biosafety Levels: Microbiology Lab
 What are the different biosafety levels (BSL) in a lab - CytoSMART Academy
What are the different biosafety levels (BSL) in a lab - CytoSMART Academy
 Biosafety levels | BSL | Latest video | Levels of Biosafety
Biosafety levels | BSL | Latest video | Levels of Biosafety
 What is Lab Biosafety - Explained in 2 Minutes
What is Lab Biosafety - Explained in 2 Minutes
 NEIDL: Biosafety Level 4
NEIDL: Biosafety Level 4
 Biosafety Lab Levels.
Biosafety Lab Levels.